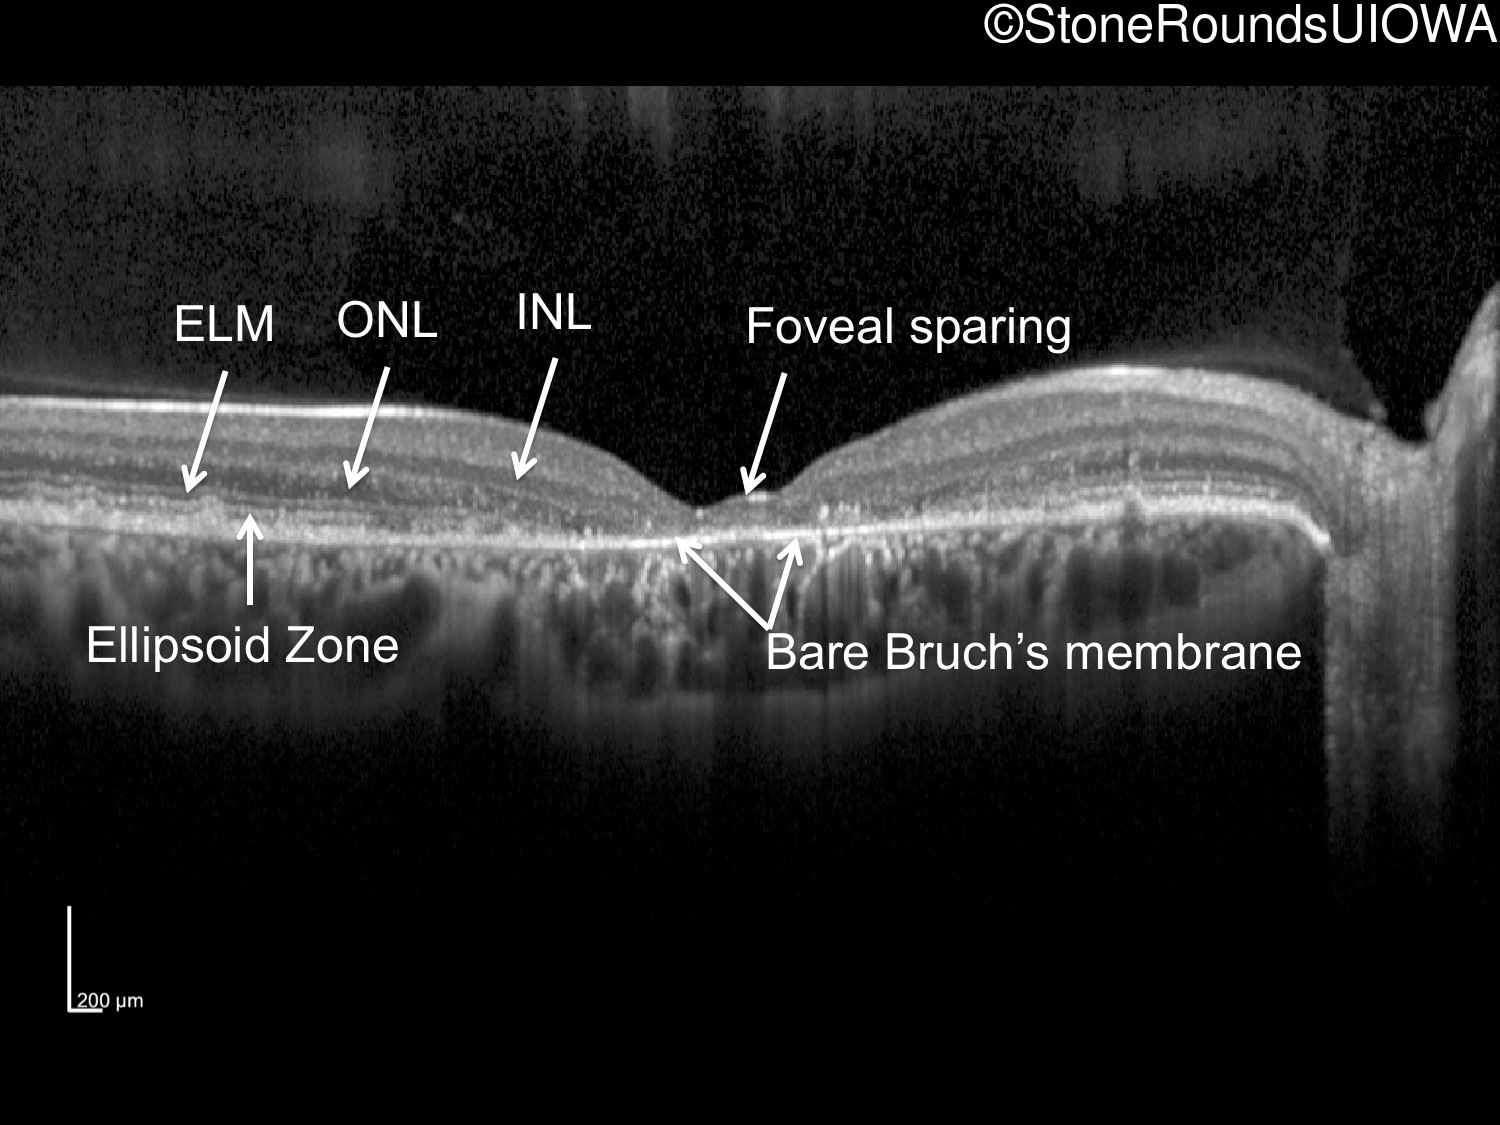
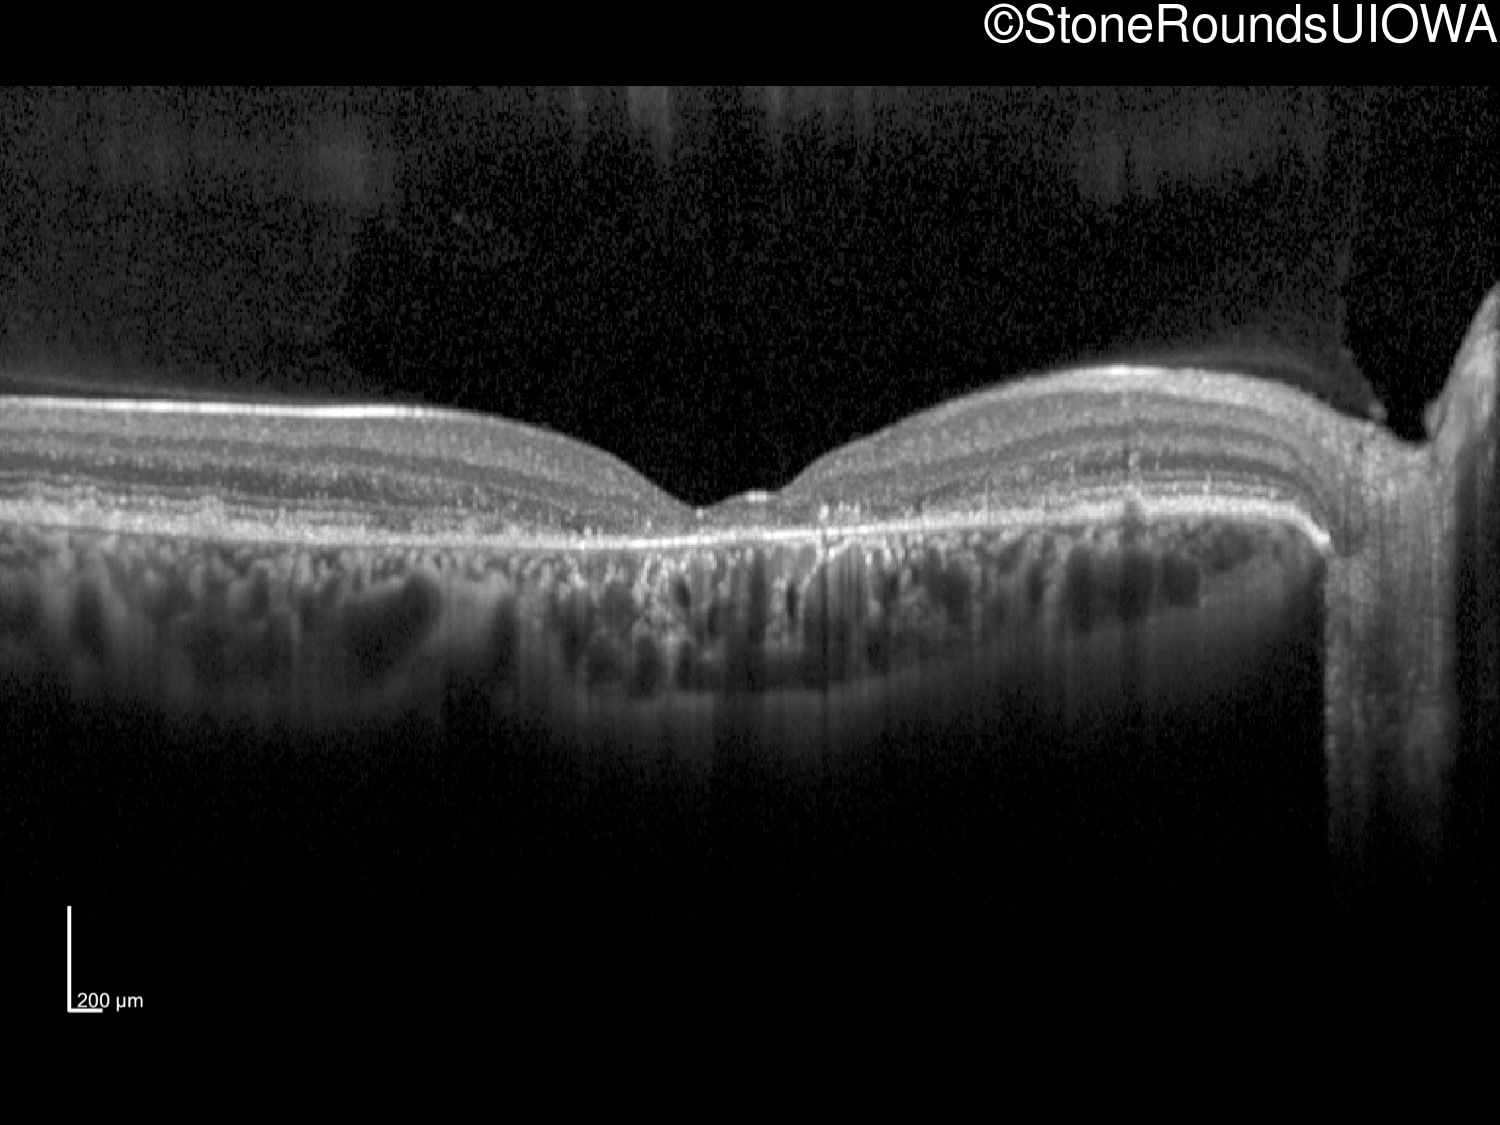
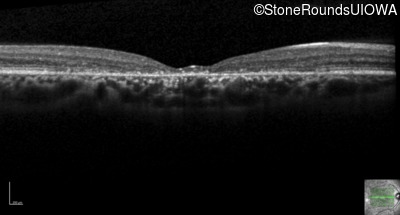
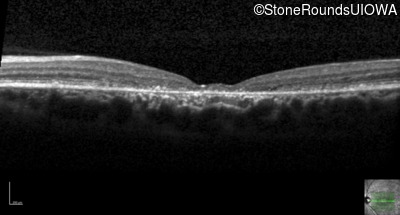
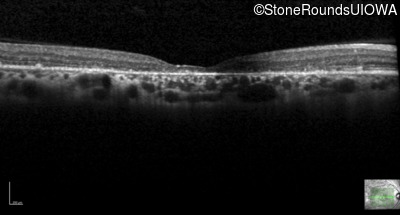
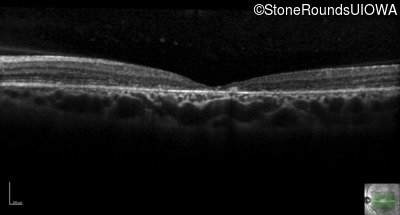
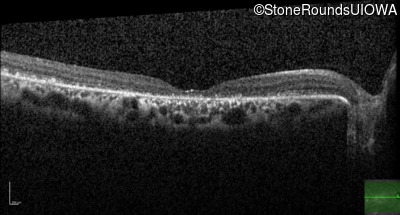
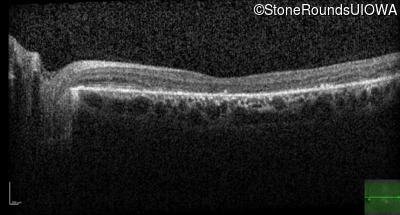
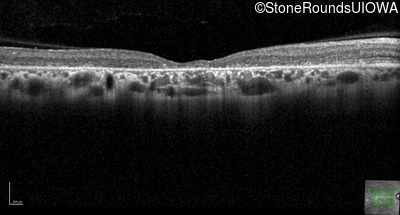
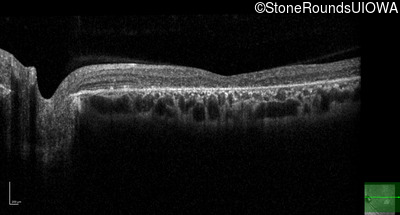
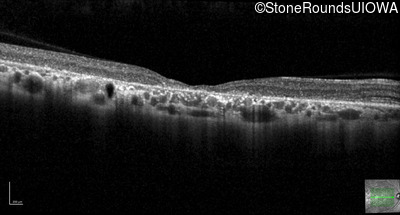
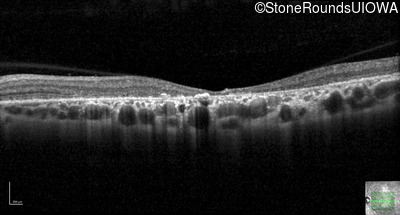

Case
SR19
Student Mode
AR Stargardt Disease (IIA)
Female
Female
Hidden
SR19
Student Mode
AR Stargardt Disease (IIA)
Female
Female
History
This 21 year old woman has a chief complaint of reduced visual acuity. She first came to medical attention at age 10 when her optometrist was unable to refract her to 20/20. Her visual acuity had been normal before that visit.
| Color Vision: | Could see the control plate but none of 12 test plates OU. |
|---|---|
| Refraction OD: | -3.00 sphere |
| Refraction OS: | -2.75 sphere |
Teaching Points
The clinical features favoring the diagnosis of ABCA4-associated autosomal recessive Stargardt disease in this patient include: loss of acuity at the beginning of the second decade, parafoveal photoreceptor loss on OCT, pisciform flecks in the macula with clear peripapillary sparing, and normally sighted parents.
All three of the cardinal ophthalmic features of Mendelian macular dystrophies are present in this patient. The most striking features of the fundus exam are the numerous yellow flecks at the level of the RPE. Flecks are most commonly seen in AR Stargardt disease and pattern dystrophy although they may be seen in some of the rarer Mendelian maculopathies as well. The visual acuity in patients with AR Stargardt disease is often "worse than the fundus looks" while the acuity in pattern dystrophy is often quite good despite extensive flecks. The pedigree of this patient is compatible with ABCA4-associated Stargardt disease and the better than expected acuity is attributable to foveal sparing (see below). The onset of reduced acuity at age 10 is much more characteristic of ABCA4 disease than pattern dystrophy. Another feature present in this patient that is very frequently seen in Stargardt disease is peripapillary sparing. However, this sign can be seen in pattern dystrophy as well. When central atrophy is present in ABCA4-associated Stargardt disease it often somewhat shiny (which is uncommon with the geographic atrophy of pattern dystrophy or age-related macular degeneration). Some patients with ABCA4-associated Stargardt disease can have some preservation of the fovea giving a zonal "bullseye" appearance to the center of the macula. Sometimes this preservation is associated with preserved acuity as in this case. The outer nuclear layer (ONL) is much thinner than normal on OCT, indicative of photoreceptor loss. This is associated with a thinning of the ellipsoid zone which is usually many times brighter and thicker than the external limiting membrane (ELM). These two lines are essentially equal in intensity in this patient. The foveal sparing is seen on OCT only as a small bit of retinal convexity in the center of the atrophy coupled with a small bit of residual RPE flanked by bare Bruch's membrane. The presence of a robust I2e isopter on Goldmann perimetry places this patient in the least severe half of all Stargardt patients (see Schindler, et al., 2010). Most patients with ABCA4-associated disease are somewhat myopic as is this patient. Stargardt patients also tend to perform very poorly on pseudoisochromatic plates, even when their acuity is still fairly good as it is here.

| Age at visit: 29 years |
| Age at visit: 33 years |
Diagnosis & molecular findings
| Disease | Gene | Allele 1 variant(s) | Allele 2 variant(s) | Inheritance mode |
|---|---|---|---|---|
| AR Stargardt Disease | ABCA4 | Ala1038Val GCC>GTC / Leu541Pro CTA>CCA | Gly863Ala (G)GA>(G)CA | AR |